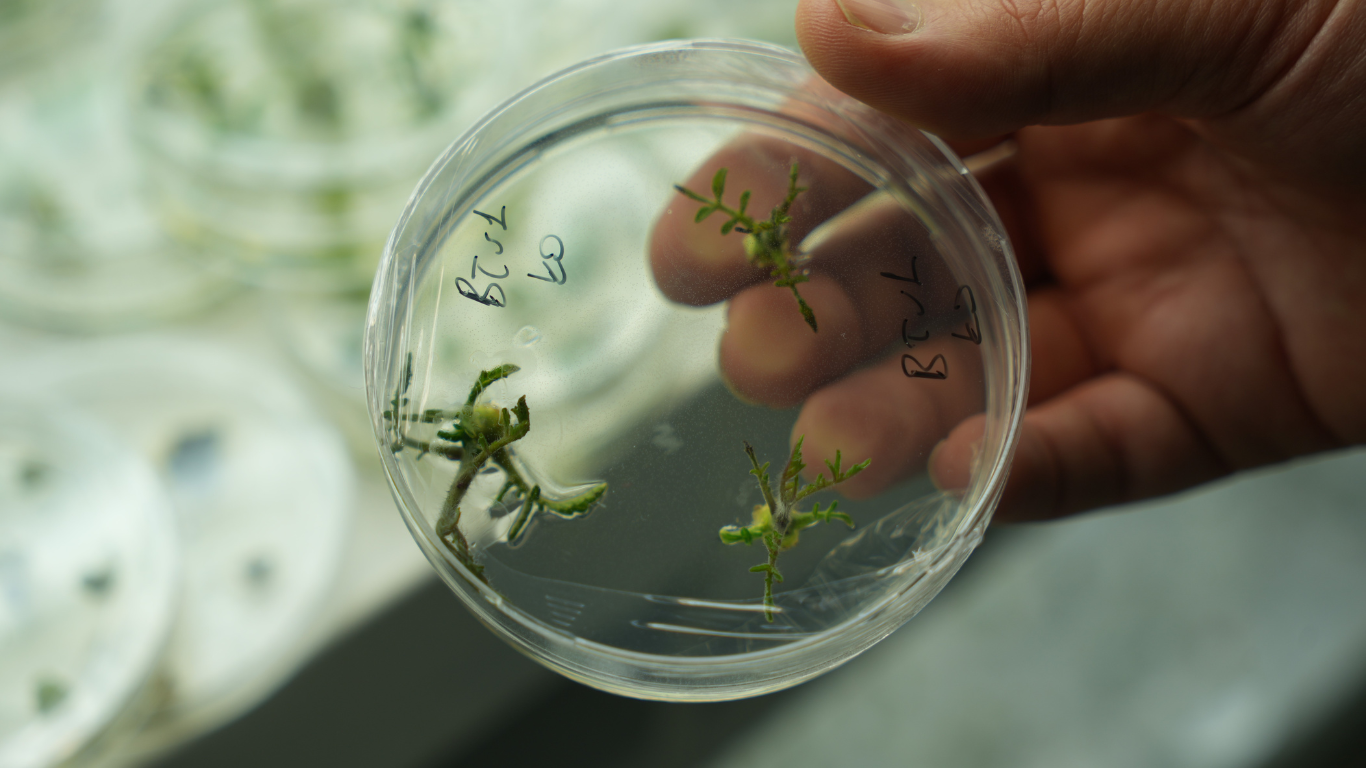
Kuraklığa Dayanıklı Domates İçin Omü’de Yeni Araştırma Başladı

İklim değişikliği tarımda ciddi riskler yaratırken, su kaynaklarının giderek azalması üreticilerin öncelikli endişeleri arasında yer alıyor. Ondokuz Mayıs Üniversitesi (OMÜ) Ziraat Fakültesi’nde yürütülen bir araştırma, özellikle domates bitkisinde kuraklığa karşı dayanıklılığı artırmayı hedefliyor. Pakistanlı doktora öğrencisi Momna Mehmood, OMÜ Tarımsal Biyoteknoloji Bölümü’nde Prof. Dr. Musa Kavas danışmanlığında yürüttüğü çalışmada, bitkilerin su stresine verdiği tepkileri ve genetik mekanizmalarını mercek altına alıyor.
Araştırmanın odak noktası, gen düzenleme yöntemiyle geliştirilen “J-03” adlı özel domates hattı. Bu domateslerde hangi genlerin kuraklık altında aktif hale geldiği, stresle başa çıkma mekanizmalarının nasıl işlediği ve geleneksel domateslere göre hangi farklılıkları gösterdiği detaylı şekilde inceleniyor. Çalışmada hem doğal domates çeşitleri hem de genetik olarak düzenlenmiş hatlar karşılaştırılarak, kuraklığa karşı dayanıklılığı artıran biyolojik süreçler ortaya çıkarılmaya çalışılıyor. Laboratuvar analizleri ve bitki ölçümleri, araştırmanın bilimsel doğruluğunu güçlendiren kritik bir veri kaynağı oluşturuyor.

Kuraklık ve Domates Üretimi
Prof. Dr. Musa Kavas, domates üretiminde kuraklığın giderek artan bir risk oluşturduğunu vurguluyor. “Yağış rejimlerindeki değişiklikler, özellikle açık arazide üretim yapan çiftçiler için verim kayıplarını artırıyor. Domatesin suya olan bağımlılığı, kuraklık koşullarında ciddi bir sorun teşkil ediyor. Amacımız, bitkinin kök ve yaprak yapısını optimize ederek suyu daha verimli kullanmasını sağlamak” diyor. Laboratuvar ortamında yapılan gen düzenlemeleri, domatesin hem kök sayısını artırarak topraktan daha fazla su almasını hem de yapraklardan su kaybını azaltmayı hedefliyor. CRISPR teknolojisi kullanılarak yürütülen bu çalışmalar, bitkinin strese karşı toleransını yükseltmeyi amaçlıyor.

Yeni Nesil Domatesler İçin Umut
Momna Mehmood, araştırmanın literatüre önemli katkılar sağlayacağını ve başarılı olması halinde domates üretiminde yeni bir dönemin başlayacağını belirtiyor. Çalışma, kuraklık koşullarına dayanıklı, suyu daha verimli kullanan ve üretim kayıplarını minimize eden domates çeşitlerinin geliştirilmesine zemin hazırlıyor. Elde edilen bulgular, gelecekte iklim değişikliğinin olumsuz etkilerine karşı daha dirençli tarım ürünleri geliştirmek için de referans niteliği taşıyacak.

OMÜ’de yürütülen bu proje, biyoteknoloji ve tarımın birleştiği noktada, sürdürülebilir üretim ve gıda güvenliği açısından önemli bir örnek teşkil ediyor. Kuraklığa dayanıklı domatesler, sadece üreticilerin değil, toplumun da ilgisini çeken bir çözüm olarak öne çıkıyor ve tarımda yenilikçi yaklaşımın somut bir göstergesi oluyor.








